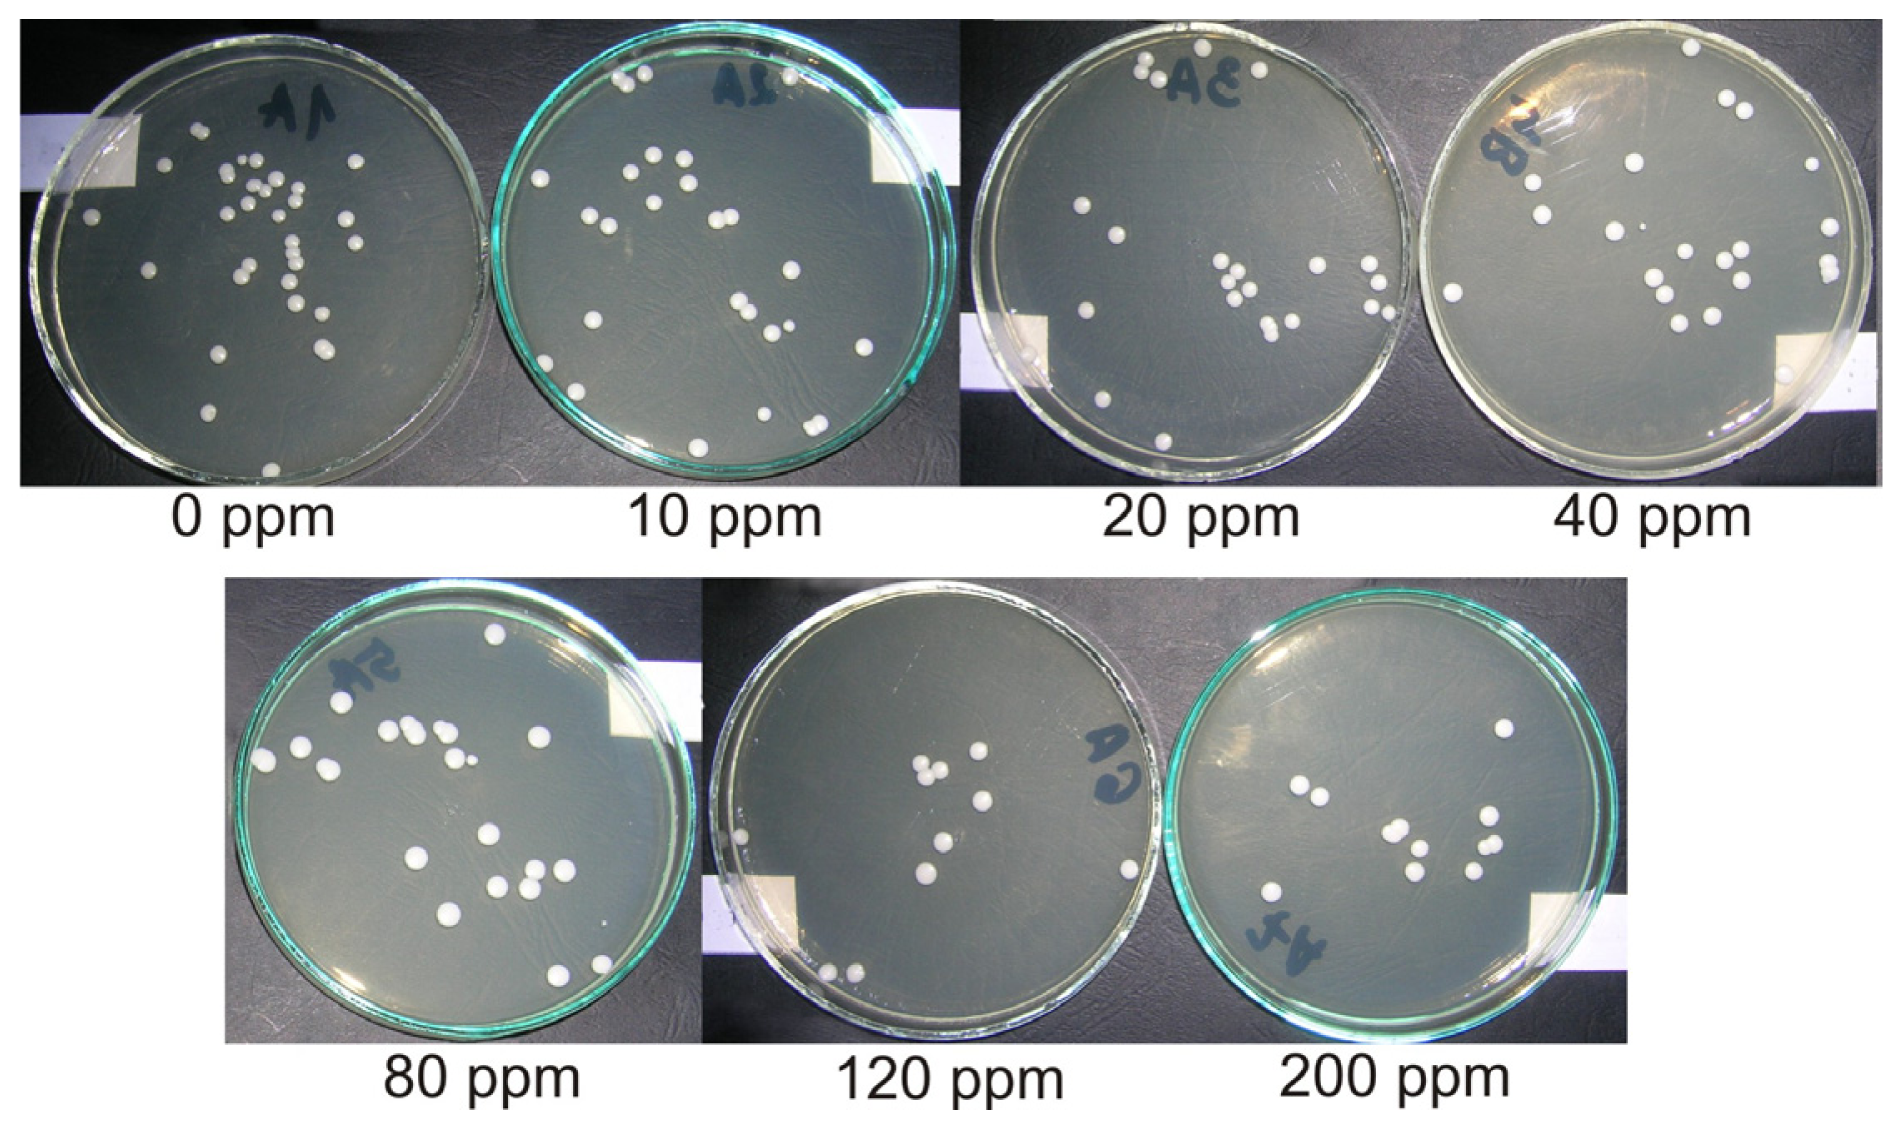
Ijms 12 04735f4

Antifungal Activity of Denture Soft Lining Material Modified by Silver Nanoparticles—A Pilot Study
Abstract
:1. Introduction
2. Results and Discussion
2.1. Material Preparation
2.2. Antifungal Activity of Studied Materials
2.3. Discussion
3. Experimental Section
3.1. Materials Preparation
3.2. Antifungal Test
4. Conclusions
Acknowledgments
References
- Budtz-Jorgensen, E; Bertram, U. Denture stomatitis 1. The etiology in relation to treatment and infection. Acta Odontol. Scand 1970, 28, 71–92. [Google Scholar]
- Ettinger, RL. The etiology of inflammatory papillary hyperplasia. J. Prosthet. Dent 1975, 34, 254–261. [Google Scholar]
- Budtz-Jorgensen, E. Oral mucosal lesions associated with the wearing of removable dentures. J. Oral. Pathol 1981, 10, 65–80. [Google Scholar]
- Spiechowicz, E; Mierzwińska-Nastalska, E. Fungal Infections of Oral Cavity, 1st ed; Med Tour Press International: Warszawa, Poland, 1998; p. 34. (in Polish) [Google Scholar]
- Bulad, K; Taylor, RL; Verran, J; McCord, JF. Colonization and penetration of denture soft lining materials by Candida albicans. Dent. Mater 2004, 20, 167–175. [Google Scholar]
- Mack, PJ. Denture soft linings: Clinical indications. Aust. Dent. J 1989, 34, 454–458. [Google Scholar]
- Chladek, G; Wrzus-Wielinski, M. The evaluation of selected attachment systems for implant-retained overdenture based on retention characteristics analysis. Acta Bioeng. Biomech 2010, 12, 75–83. [Google Scholar]
- Burns, DR; Bruns, DA; Dipietro, GJ; Gregory, RL. Response of processed resilient denture liners to Candida albicans. J. Prosthet. Dent 1987, 57, 507–512. [Google Scholar]
- Graham, BS; Jones, DW; Burkee, J; Thompson, JP. In vivo fungal presence and growth on two resilient denture liners. J. Prosthet. Dent 1991, 65, 528–531. [Google Scholar]
- Nikawa, H; Chen, J; Hamada, T. Interactions between thermal cycled resilient denture lining materials, salivary and serum pellicles and Candida albicans in vitro. Part I. Effects on fungal growth. J. Oral. Rehabil 2000, 27, 41–51. [Google Scholar]
- Nikawa, H; Hamada, T; Yamamoto, T; Kumagai, H. Effects of salivary or serum pellicles on the Candida albicans growth and biofilm formation on soft lining materials in vitro. J. Oral. Rehabil 1997, 24, 594–604. [Google Scholar]
- Nikawa, H; Hayashi, S; Nikawa, Y; Hamada, T; Samaranayake, LP. Interactions between denture lining material, protein pellicles and Candida albicans. Arch. Oral. Biol 1993, 38, 631–634. [Google Scholar]
- Nikawa, H; Chen, J; Hamada, T; Makihira, S; Kumagai, H; Murata, H. Interactions between thermal cycled resilient denture lining materials, salivary and serum pellicles and Candida albicans in vitro. Part II. Effects on fungal colonization. J. Oral. Rehabil 2000, 27, 124–130. [Google Scholar]
- Verran, J; Maryan, CJ. Retention of Candida albicans on acrylic resin and silicone of different surface topography. J. Prosthet. Dent 1997, 77, 535–539. [Google Scholar]
- Waters, MGJ; Williams, DW; Jagger, RG; Lewis, MAO. Adherence of Candida albicans to experimental denture soft lining materials. J. Prosthet. Dent 1997, 77, 306–312. [Google Scholar]
- Massella, RP; Dolan, CT; Laney, WR. The prevention of growth of Candida on silastic 390 soft liner for dentures. J. Prosthet. Dent 1975, 33, 250–257. [Google Scholar]
- Wang, G; Zreiqat, H. Functional coatings or films for hard-tissue applications. Materials 2010, 3, 3994–4050. [Google Scholar]
- Yamamoto, K; Ohashi, S; Aono, M; Kokubo, T; Yamada, I; Yamauchi, J. Antibacterial activity of silver ions implanted in SiO2 filler on oral streptococci. Dent. Mater 1996, 12, 227–229. [Google Scholar]
- Kawashita, M; Tsuneyama, S; Miyaji, F; Kokubo, T; Kozuka, H; Yamamoto, K. Antibacterial silver-containing silica glass prepared by sol–gel method. Biomaterials 2000, 21, 393–398. [Google Scholar]
- Hotta, M; Nakajima, H; Yamamoto, K; Aono, M. Antibacterial temporary filling materials: The effect of adding various ratios of Ag–Zn–zeolite. J. Oral. Rehabil 1998, 25, 485–489. [Google Scholar]
- Syafiuddin, T; Hisamitsu, H; Toko, T; Igarashi, T; Goto, N; Fujishima, A; Miyazaki, T. In vitro inhibition of caries around a resin composite restoration containing antibacterial filler. Biomaterials 1997, 18, 1051–1057. [Google Scholar]
- Yoshida, K; Tanagawa, M; Atsuta, M. Characterization and inhibitory effect of antibacterial dental resin composites incorporating silver-supported materials. J. Biomed. Mater. Res 1999, 47, 516–522. [Google Scholar]
- Fan, C; Chu, L; Rawls, HR; Norling, BK; Cardenas, HL; Whang, K. Development of an antimicrobial resin—A pilot study. Dent. Mater 2011, 27, 322–328. [Google Scholar]
- Dorjnamjin, D; Ariunaa, M; Shim, YK. Synthesis of silver nanoparticles using hydroxyl functionalized ionic liquids and their antimicrobial activity. Int. J. Mol. Sci 2008, 9, 807–820. [Google Scholar]
- Nikawa, H; Jin, C; Makihira, S; Egusa, H; Hamada, T; Kumagai, H. Biofilm formation of Candida albicans on the surface of denture lining materials caused by denture cleansers in vitro. J. Oral. Rehabil 2003, 30, 243–250. [Google Scholar]
- Pavan, S; dos Santos, PH; Filho, JN; Spolidorio, DM. Colonisation of soft lining materials by micro-organisms. Gerodontology 2010, 27, 211–216. [Google Scholar]
- Tari, BF; Nalbant, D; Dogruman Al, F; Kustimur, S. Surface roughness and adherence of Candida albicans on soft lining materials as influenced by accelerated aging. J. Contemp. Dent. Pract 2007, 8, 18–25. [Google Scholar]
- Taylor, RL; Bulad, K; Verran, J; McCord, JF. Colonization and deterioration of soft denture lining materials in vivo. Eur. J. Prosthodont. Restor. Dent 2008, 16, 50–55. [Google Scholar]
- Panácek, A; Kolár, M; Vecerová, R; Prucek, R; Soukupová, J; Krystof, V; Hamal, P; Zboril, R; Kvítek, L. Antifungal activity of silver nanoparticles against Candida spp. Biomaterials 2009, 30, 6333–6340. [Google Scholar]
- Nasrollahi, A; Pourshamsian, K; Mansourkiaee, P. Antifungal activity of silver nanoparticles on some of fungi. Int. J. Nano. Dim 2011, 1, 233–239. [Google Scholar]
- Ozdemir, I; Ozcan, EO; Günal, S; Gürbüz, N. Synthesis and antimicrobial activity of novel Ag-N-hetero-cyclic carbene complexes. Molecules 2010, 15, 2499–2508. [Google Scholar]
- Kim, KJ; Sung, WS; Suh, BK; Moon, SK; Choi, JS; Kim, JG; Lee, DG. Antifungal activity and mode of action of silver nano-particles on Candida albicans. Biometals 2009, 22, 235–242. [Google Scholar]
- Kvitek, L; Panacek, A; Prucek, R; Soukupova, J; Vanickova, M; Kolar, M; Zboril, R. Antibacterial activity and toxicity of silver—Nanosilver versus ionic silver. J. Phys.: Conf. Ser 2011, 304, 012029. [Google Scholar]
- Chaloupka, K; Malam, Y; Seifalian, AM. Nanosilver as a new generation of nanoproduct in biomedical applications. Trends Biotechnol 2010, 28, 580–588. [Google Scholar]
- Chen, X; Schluesener, HJ. Nanosilver: A nanoproduct in medical application. Toxicol Lett 2008, 176, 1–12. [Google Scholar]
- Miura, N; Shinohara, Y. Cytotoxic effect and apoptosis induction by silver nanoparticles in HeLa cells. Biochem. Biophys. Res. Commun 2009, 390, 733–737. [Google Scholar]
- Xu, X; Yang, Q; Wang, Y; Yu, H; Chen, X; Jing, X. Biodegradable electrospun poly(L-lactide) fibers containing antibacterial silver nanoparticles. Eur. Polym. J 2006, 42, 2081–2087. [Google Scholar]

| AgNPs ppm | CFU/mL (Vt) ×103 | SD ×103 | AFE | SD |
|---|---|---|---|---|
| 0 | 1.43 | 0.22 | 0% | - |
| 10 | 0.96 | 0.16 | 16.3% | 6.2% |
| 20 | 0.87 | 0.04 | 24.2% | 3.5% |
| 40 | 0.79 | 0.04 | 31.5% | 3.1% |
| 80 | 0.74 | 0.06 | 36.6% | 5.4% |
| 120 | 0.60 | 0.07 | 47.8% | 6.3% |
| 200 | 0.55 | 0.07 | 52.2% | 6.2% |
| Vc (BLANK) | 1.15 | - | - | - |
© 2011 by the authors; licensee MDPI, Basel, Switzerland. This article is an open-access article distributed under the terms and conditions of the Creative Commons Attribution license (http://creativecommons.org/licenses/by/3.0/).
Share and Cite
Chladek, G.; Mertas, A.; Barszczewska-Rybarek, I.; Nalewajek, T.; Żmudzki, J.; Król, W.; Łukaszczyk, J. Antifungal Activity of Denture Soft Lining Material Modified by Silver Nanoparticles—A Pilot Study. Int. J. Mol. Sci. 2011, 12, 4735-4744. https://doi.org/10.3390/ijms12074735
Chladek G, Mertas A, Barszczewska-Rybarek I, Nalewajek T, Żmudzki J, Król W, Łukaszczyk J. Antifungal Activity of Denture Soft Lining Material Modified by Silver Nanoparticles—A Pilot Study. International Journal of Molecular Sciences. 2011; 12(7):4735-4744. https://doi.org/10.3390/ijms12074735
Chicago/Turabian StyleChladek, Grzegorz, Anna Mertas, Izabela Barszczewska-Rybarek, Teresa Nalewajek, Jarosław Żmudzki, Wojciech Król, and Jan Łukaszczyk. 2011. "Antifungal Activity of Denture Soft Lining Material Modified by Silver Nanoparticles—A Pilot Study" International Journal of Molecular Sciences 12, no. 7: 4735-4744. https://doi.org/10.3390/ijms12074735
APA StyleChladek, G., Mertas, A., Barszczewska-Rybarek, I., Nalewajek, T., Żmudzki, J., Król, W., & Łukaszczyk, J. (2011). Antifungal Activity of Denture Soft Lining Material Modified by Silver Nanoparticles—A Pilot Study. International Journal of Molecular Sciences, 12(7), 4735-4744. https://doi.org/10.3390/ijms12074735

